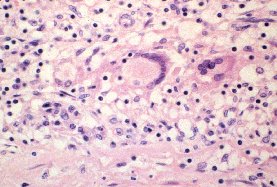
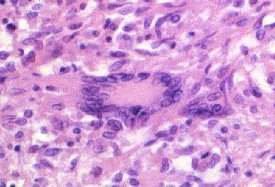
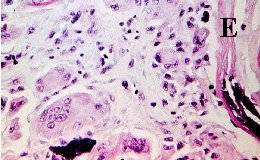

Slides showing chronic inflammation are commonly encountered
in the examination. Very often the examiner will show you slide containing
giant cells as in chalazion, giant
cell arteritis, sarcoidosis or tuberculoma.
Giant cells are transformed macrophages. There are three main types
of giant cells seen in chronic inflammation and each has a typical histopathological
feature. (Note: while giant cells are characteristic of granuloma, a granulatomatous
lesion can still be diagnosed without their presence):
-
Langharn's cell: the giant cell has a peripheral ring (horseshoe)
of nuclei in the cytoplasm
-
Foreign body giant cell: the nuclei are centrally placed and overlap
each other
-
Touton's cells: there is a ring of nuclei separating a peripheral
clear cytoplasma from an eosinophilic central cytoplasm. Slide showing
typical Touton's cells are rare but you may be shown pictures of juvenile
xanthogranuloma (skin or iris) followed by a discussion of its histopathological
feature.